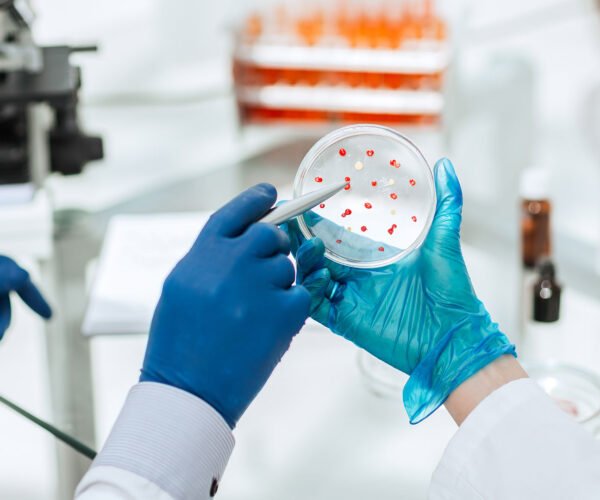

mednix Innovation Through Research.
Trusted Research, Proven Results.
From experimental design to advanced analysis, we deliver research that drives meaningful change. Our modern facilities support multidisciplinary research
mednix Reliable Diagnostic Testing
Modern Laboratory Reliable Research.
From experimental design to advanced analysis, we deliver research that drives meaningful change. Our modern facilities support multidisciplinary research
Our Laboratory Story
Advancing Science in Our Laboratory
We are a multidisciplinary laboratory dedicated to high-quality research, testing, and innovation. Our mission is to provide accurate results.

Laboratory Data Analysis

Customized Testing Solutions
- Every result we deliver is precise, validated, and reproducible.
- Ethical research and transparency guide all our operations.

Research Services
Our Advanced Research and Laboratory Services

A biochemistry solution is a prepared liquid that contains biochemical substances used for various scientific and medical applications.

It involves diagnosing and treating conditions such as anemia, leukemia, and other related disorders.
Molecular diagnostics is a technique used to detect and analyze genetic material (DNA or RNA) to diagnose and monitor diseases, identify risk, and guide treatment decisions.

Microbiology is the study of microorganisms, including bacteria, viruses, fungi, and parasites. It focuses on their structure, function, and role in health, disease, and the environment.

It involves examining tissues, organs, and bodily fluids to diagnose medical conditions.

Immunology is the study of the immune system and how it protects the body from disease.
Why Choose Us

The Advantages of Choosing Our Laboratory
Advanced Equipment
High-precision instruments for accurate and reliable results.
Quality & Compliance
Strict adherence to international standards and ethical practices.
Collaborative Research
Partnering with academia, industry, and healthcare organizations.
Expert Research Team
Skilled scientists and technicians across multiple disciplines.
Healthcare Professionals
Our Medical Expert Doctors Supporting Your Tests
Our Impactful
Research
4.9
"The medical team is incredibly knowledgeable and thorough. I felt confident in their care every step of the way. I'm so thankful for their expertise. I always check Healthline when I have a question about symptoms, medications, or diet. The articles are reviewed by professionals, and I like that they cite their sources. It feels trustworthy and not too overwhelming."

Arietta Preston
"The medical team is incredibly knowledgeable and thorough. I felt confident in their care every step of the way. I'm so thankful for their expertise. I always check Healthline when I have a question about symptoms, medications, or diet. The articles are reviewed by professionals, and I like that they cite their sources. It feels trustworthy and not too overwhelming."

Xeinna Chris
"The medical team is incredibly knowledgeable and thorough. I felt confident in their care every step of the way. I'm so thankful for their expertise. I always check Healthline when I have a question about symptoms, medications, or diet. The articles are reviewed by professionals, and I like that they cite their sources. It feels trustworthy and not too overwhelming."

Sapphire Rose
"The medical team is incredibly knowledgeable and thorough. I felt confident in their care every step of the way. I'm so thankful for their expertise. I always check Healthline when I have a question about symptoms, medications, or diet. The articles are reviewed by professionals, and I like that they cite their sources. It feels trustworthy and not too overwhelming."

Arietta Preston
"The medical team is incredibly knowledgeable and thorough. I felt confident in their care every step of the way. I'm so thankful for their expertise. I always check Healthline when I have a question about symptoms, medications, or diet. The articles are reviewed by professionals, and I like that they cite their sources. It feels trustworthy and not too overwhelming."

Xeinna Chris
"The medical team is incredibly knowledgeable and thorough. I felt confident in their care every step of the way. I'm so thankful for their expertise. I always check Healthline when I have a question about symptoms, medications, or diet. The articles are reviewed by professionals, and I like that they cite their sources. It feels trustworthy and not too overwhelming."

Sapphire Rose
Sample Rates
Affordable Pricing Plan
Basic
Choose the plan that best fits your needs.
- Comprehensive testing
- Detailed analytical report
- Consultation with lab specialist
- 1–2 business day turnaround
$77
/ per samplePremium
Choose the plan that best fits your needs.
- Full-spectrum analysis
- Customized research report
- Expert recommendations
- Access to digital results portal













